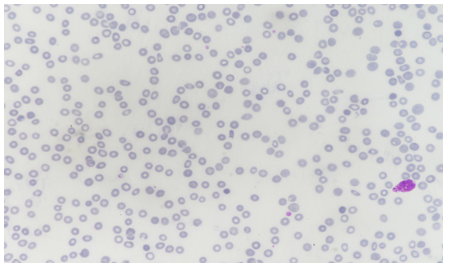

>Corresponding Author : Mandeep Lohan
>Article Type : Case Report
>Volume : 3 | Issue : 5
>Received Date : 01 Aug, 2023
>Accepted Date : 25 Aug, 2023
>Published Date : 30 Aug, 2023
>DOI : https://doi.org/10.54289/JCRMH2300125
>Citation : Jain R, Attri S and Lohan M. (2023) Febuxostat Induced Pancytopenia. J Case Rep Med Hist 3(5): doi https://doi.org/10.54289/JCRMH2300125
>Copyright : © 2023 Jain R, et al. This is an open-access article distributed under the terms of the Creative Commons Attribution License, which permits unrestricted use, distribution, and reproduction in any medium, provided the original author and source are credited.
Case Report | Open Access | Full Text
1Department Of Medicine, Government Medical College and Hospital, Sector 32, Chandigarh, India
2Assistant Professor, Department of General Medicine, Government Medical College and Hospital, Sector 32, Chandigarh, India
3Junior Resident, Department of General Medicine, Government Medical College and Hospital, Sector 32, Chandigarh, India
*Corresponding author: Mandeep Lohan, Junior Resident, Department of General Medicine, Government Medical College and Hospital, Sector 32, Chandigarh, India
Abstract
Febuxostat is a xanthine oxidase inhibitor commonly used for the treatment of hyperuricemia in patients with gout. We present the case of a 65-year-old male patient who developed bone marrow suppression following 2 years of febuxostat therapy for the management of gout. While it is generally well-tolerated, rare cases of bone marrow suppression have been reported. This case highlights the importance of monitoring complete blood counts in patients on febuxostat therapy and considering bone marrow suppression as a potential adverse effect.
Introduction
Febuxostat, a non-purine selective inhibitor of xanthine oxidase, has emerged as an effective alternative to allopurinol for the management of hyperuricemia in patients with gout. It lowers serum uric acid levels by inhibiting xanthine oxidase, the enzyme responsible for the production of uric acid. Although febuxostat is generally considered safe, there have been reports of rare adverse effects, including bone marrow suppression. Here, we describe a case of bone marrow suppression in a patient receiving febuxostat therapy.
Case presentation
A 65-year-old male with a history of gout presented to the clinic with complaints of persistent fatigue, pallor, and easy bruising. He was on febuxostat 80 mg once daily for 2 years for the management of gout. Laboratory investigations demonstrated severe pancytopenia, with a hemoglobin level of 8.6 g/dL (reference range: 13-16g/dL), white blood cell count of 2.9 × 10^9/L (reference range: 4.0-10.0 × 10^9/L), and platelet count of 138 × 10^9/L (reference range: 150-400 × 10^9/L).
Further investigations, including liver and renal function tests, vitamin B12, and folate levels, were within normal limits. Hemolysis workup, including the Coombs test and LDH, was negative.

Table 1
During the course of next week, counts further destabilized to a hemoglobin level of 5.6 g/dL (reference range: 13-16g/dL), white blood cell count of 2.6 × 10^9/L (reference range: 4.0-10.0 × 10^9/L), and platelet count of 50 × 10^9/L (reference range: 150-400 × 10^9/L). Physical examination now revealed pallor and ecchymoses on the extremities.

Table 2
Diagnostic Assessment
The patient's medical history, clinical presentation, and laboratory findings raised concerns about bone marrow suppression. Further investigations were performed to identify the cause. Peripheral blood smear examination revealed normocytic normochromic red blood cells with reduced platelet count and decreased leukocyte population. Bone marrow aspiration and biopsy were performed to evaluate the bone marrow function and morphology. The bone marrow examination showed “Maturation Arrest” with normo to hypercellular cellular marrow with decreased cellularity and reduced myeloid-to-erythroid ratio Ret count 0.6. There was no evidence of infiltrative or neoplastic processes.
Treatment and Follow-up
Upon confirmation of bone marrow suppression, febuxostat was immediately discontinued, and the patient was started on supportive care, including red blood cell transfusions and broad-spectrum antibiotics to prevent infection.
Regular complete blood counts were monitored to assess hematological recovery. Over the subsequent weeks, the patient showed gradual improvement in blood counts. Hemoglobin levels, white blood cell count, and platelet count returned to normal ranges within three months. The patient was advised against reinitiating febuxostat due to the risk of recurrence and monitored CBC.
Discussion
In more than 40 years, febuxostat is the first medication for the treatment of gout to be FDA-approved and sold. For patients who cannot take or tolerate the less expensive and better-researched allopurinol, it represents a new option for the treatment of hyperuricemia and gout [1]. Bone marrow suppression is a very rare adverse effect associated with febuxostat therapy. A review of the literature revealed several case reports documenting febuxostat-induced bone marrow suppression [2,3]. The mechanism underlying this adverse effect remains unclear. It is hypothesized that febuxostat or its metabolites may have a direct toxic effect on hematopoietic stem cells or interfere with the bone marrow microenvironment [2], leading to the suppression of hematopoiesis. Improvement after stopping the offending agent led to improvement in another case Poh XE et al [4]. The incidence of bone marrow suppression with febuxostat therapy is estimated to be less than 1% acc to a study conducted by Zhang Y et al [3].
Conclusion
This case report highlights the importance of recognizing the potential for bone marrow suppression as an adverse effect of febuxostat therapy. Monitoring complete blood counts at regular intervals is essential to detect and manage this rare complication. Healthcare professionals should be vigilant in evaluating patients on febuxostat therapy who present with unexplained fatigue, pallor, or bleeding manifestations. Prompt discontinuation of febuxostat and initiation of supportive care can facilitate hematological recovery and prevent further complications associated with bone marrow suppression.

Figure 1: Mega 10x

Figure 2: Trephine Biopsy
Figure 3: Peripheral Blood Film
References
- Avena-Woods C, Hilas O. (2010) Febuxostat (Uloric), A New Treatment Option for Gout. P T. 35(2): 82-85. [Ref.]
- Kobayashi S, Ogura M, Hosoya T. (2013) Acute neutropenia associated with initiation of febuxostat therapy for hyperuricemia in patients with chronic kidney disease. Journal of clinical pharmacy and therapeutics. 38(3): 258-261. [PubMed.]
- Park S, Jee D, Kim H. (2019) General anesthesia for patient with Fahr's syndrome: A case report. Medicine (Baltimore). 98(17): e15390. [PubMed.]
- Poh XE, Lee CT, Pei SN. (2017) Febuxostat-induced agranulocytosis in an end-stage renal disease patient: A case report. Medicine (Baltimore). 96(2): e5863. [PubMed.]